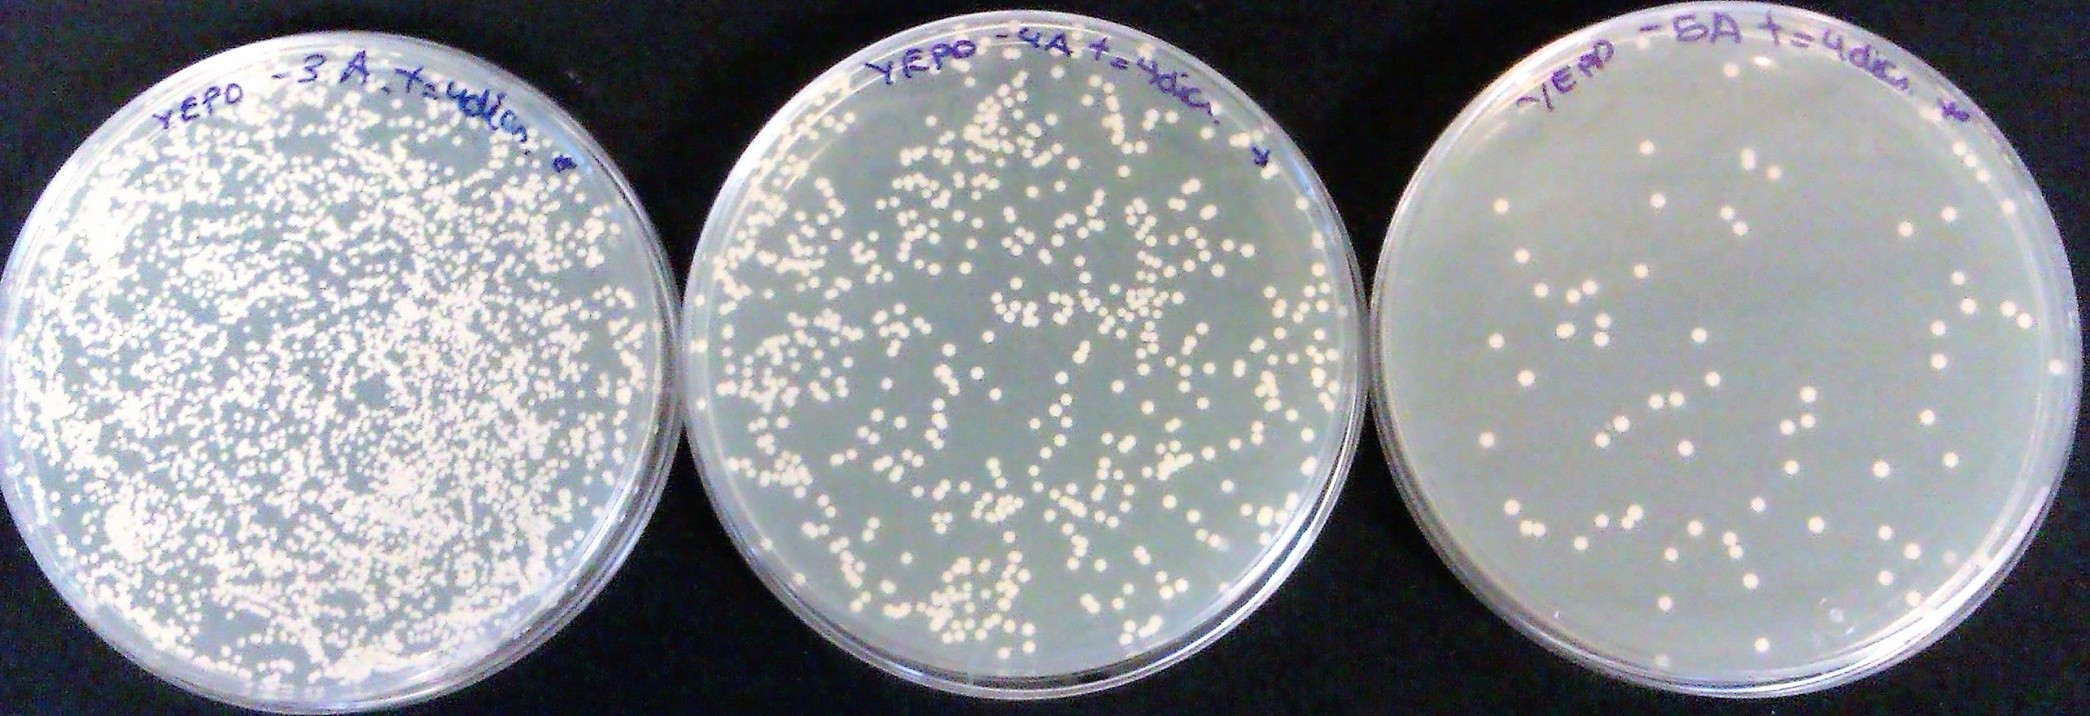

- Profesor: Xestión Centro de Posgrao e Formación Permanente
- Profesor: María Inmaculada Franco Matilla
- Profesor: María José Pérez Álvarez
- Profesor: Xestión Centro de Posgrao e Formación Permanente
- Profesor: Maria Dolores Fernandez Marcos
- Profesor: Antonio Freire Magariños
- Profesor: Pablo García Vivanco
- Profesor: Francisco De Paula Maraver Eyzaguirre
- Profesor: Rosa María Meijide Failde
- Profesor: María José Pérez Álvarez
- Profesor: Salvador Ramos Rey
- Profesor: María Del Carmen Valenzuela Rico
- Profesor: Maria Lorena Vela Iglesias
- Profesor: Xestión Centro de Posgrao e Formación Permanente
- Profesor: Maria Dolores Fernandez Marcos
- Profesor: Antonio Freire Magariños
- Profesor: Juan Jesús Gestal Otero
- Profesor: Francisco De Paula Maraver Eyzaguirre
- Profesor: Eder Peña Quimbaya
- Profesor: María José Pérez Álvarez
- Profesor: María Del Carmen Valenzuela Rico
- Profesor: Maria Lorena Vela Iglesias
- Profesor: Xestión Centro de Posgrao e Formación Permanente
- Profesor: Herminia Domínguez González
- Profesor: Elena Falqué López
- Profesor: Carmen Paula Gómez Pérez
- Profesor: María Lourdes Mourelle Mosqueira
- Profesor: María José Pérez Álvarez
Formación en Dermocosmética termal.
- Estudo da pel.
- Cosmética termal: composición dos cosméticos elaborados con augas minero-medicinais.
- Profesor: Xestión Centro de Posgrao e Formación Permanente
- Profesor: Carmen Paula Gómez Pérez
- Profesor: María Lourdes Mourelle Mosqueira
- Profesor: María José Pérez Álvarez
- Profesor: MARÍA DOLORES TORRES PÉREZ
- Profesor: Xestión Centro de Posgrao e Formación Permanente
- Profesor: María Inmaculada Franco Matilla
- Profesor: Carmen Paula Gómez Pérez
- Profesor: José Luís Legido Soto
- Profesor: Eder Peña Quimbaya
- Profesor: María José Pérez Álvarez
- Profesor: Roberto Orlando Bustillo Bolado
- Profesor: Xestión Centro de Posgrao e Formación Permanente
- Profesor: Sofía Salgado Pontón
- Profesor: Julia Carballo Rodríguez
- Profesor: Xestión Centro de Posgrao e Formación Permanente
- Profesor: María José Pérez Álvarez

- Profesor: Xestión Centro de Posgrao e Formación Permanente
- Profesor: Elena Falqué López
- Profesor: María de la Concepción Pérez Lamela
